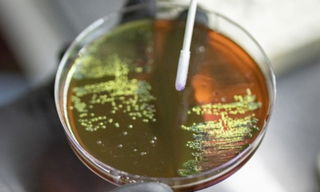

Early action against the rising antimicrobial resistance (AMR) is needed to ensure infections remain treatable, and surgeries stay safe, said the World Health Organization (WHO), during the World AMR Awareness Week, on Friday. ...

Andhra Pradesh Chief Minister N Chandrababu Naidu on Friday clarified that the medical colleges being developed in Public Private Partnership (PPP) mode will run under the jurisdiction and supervision of the state government. ...

South Korea has pledged to contribute $100 million to the Global Fund for three years, beginning in 2026, reaffirming its commitment to international efforts to combat major infectious diseases, according to the foreign ministry on Saturday. ...

World-class infrastructure, unique surgical expertise, and robust regulation have driven the number of liver don...

The Maharaja Yeshwantrao (MY) Hospital administration has suspended a nursing officer, and disciplinary action has been initiated against two nursing staffers after a five-member inquiry committee confirmed the allegation that an expired intravenous (IV) antibiotic was administered to a female ...

Localising strategies to adapt to diverse needs and making precision policy is crucial to boost family planning in India, said senior government officials here. ...

India has made significant progress in reducing poverty, and the country’s flagship programmes have supported investments in children, according to the UNICEF on Thursday. ...

Rajasthan Medical and Health Department, intensifying its focus on strengthening healthcare quality and ensuring better services for the public, is adopting a zero-tolerance policy toward negligence or irregularities. ...

India has advanced cooperation with Germany in the field of traditional and integrative healthcare, the Ministry of Ayush said. ...

The Central Drugs Standard Control Organisation (CDSCO) on Friday declared 211 drug samples tested by the Central and state drugs regulatory authorities as ‘Not of Standard Quality (NSQ)' in its monthly drug alert for October. ...